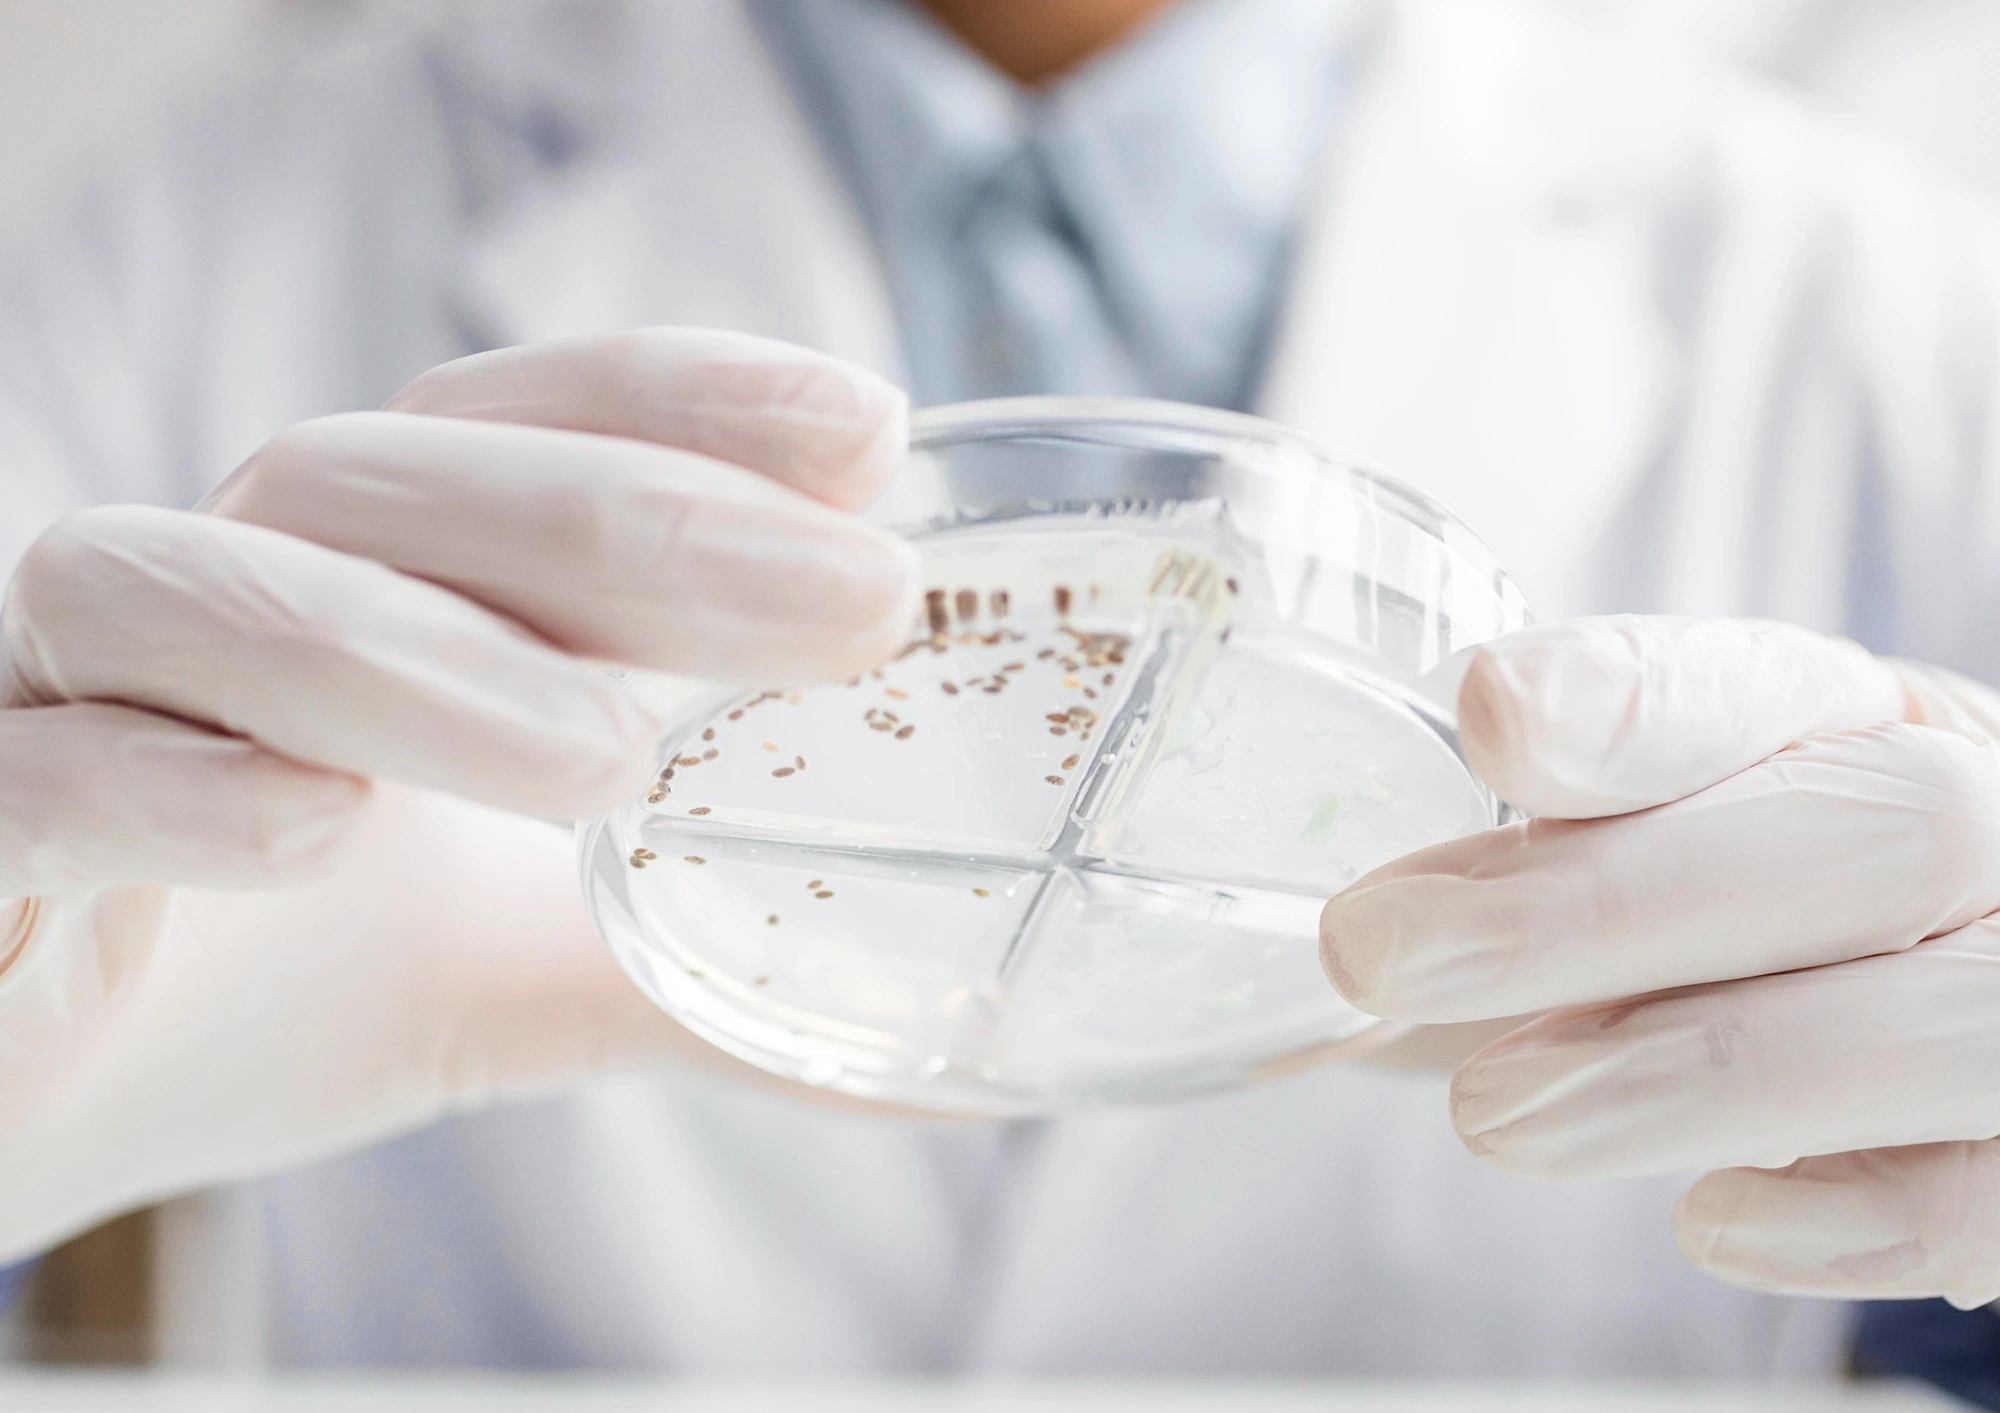

Молочные продукты будущего: что изменится внутри упаковки. Часть 1
Предпочтения потребителей меняются каждый год, поэтому производители придумывают не только новые вкусы, но и технологии производства. Разбираемся, что мы увидим на полках магазинов в ближайшем будущем, вместе с Натальей Земцовой, пищевым технологом, менеджером R&D и автором телеграм-канала «R&D кухня Натальи Земцовой».

Безлактозные продукты
На полках магазинов много продуктов с приставкой «безлактозные», и напитков на растительной основе, которые не содержат казеин.
Обычно за основу берут, овес, гречку, миндаль, кокос и сою, но производители постоянно расширяют продуктовую линейку. Например, бренд Planto выпускает молочные напитки на растительной основе с оригинальными вкусами: фисташковый пломбир, банан, карамель.
Такое молоко — отличная основа для кофейных напитков, смузи и полезных завтраков. Поэтому производители разрабатывают напитки не только с новыми вкусами, но и свойствами.
Гидролизаты сывороточного протеина
Гидролизаты сывороточного белка — это органические белки, которые получают путем расщепления молочного белка на мелкие пептиды. Благодаря этому белок усваивается быстрее и проще. В большинстве случаев их используют для производства детского, лечебного и спортивного питания.

У производства молочных продуктов по такой технологии есть ряд ограничений:
- гидролизованные белки оставляют горький привкус, который трудно замаскировать;
- высокая стоимость по сравнению с традиционными молочными продуктами;
- повышенное содержание белка может негативно повлиять на здоровье людей с заболеваниями почек.
По степени гидролиза выделяют три степени: гидролизаты с низкой, средней и высокой степенью гидролиза. Чем выше степень, тем более горький вкус у продукта. По прогнозам, рынок продукта будет расти, несмотря на трудности.
Йогурты, которые хранятся при комнатной температуре
Люди все чаще выбирают натуральные и полезные продукты, которые долго не портятся. Такие йогурты удобно хранить и брать с собой в дорогу, например, на работу или пикник.
Наталья Земцова, пищевой технолог, менеджер R&D и автор телеграм-канала «R&D кухня Натальи Земцовой»:
Сегодня есть такие молочные продукты, как ультрапастеризованное молоко. Для хранения молока при комнатной температуре важно отсутствие микрофлоры как первой причины порчи пищевого продукта.
Ультрапастеризованное молоко проходит высокотемпературную обработку в течение нескольких секунд. Такой способ уничтожает микроорганизмы, но при этом сохраняет вкус и пищевую ценность молока. В сочетании с асептическим розливом продукта в герметичную упаковку, молоко можно хранить при комнатной температуре до 6 месяцев.
Но как только потребитель вскрывает упаковку, нарушаются защитные свойства, и молоко следует хранить уже в холодильнике.
Также Наталья говорит, что существуют термизированные йогурты. В технологии их изготовления также используются специальная термическая обработка с асептическим розливом, поэтому они могут храниться до года при комнатной температуре. Такие йогурты не обладают лечебным эффектом, но имеют высокую пищевую ценность.

Есть интерес к сырам, которые хранятся в условиях комнатной температуры. Их удобно взять с собой в дальнюю поездку, на дачу и в туристический поход. Сделать такой сыр без высокотемпературной обработки нельзя, поэтому существуют плавленые стерилизованные сыры в жестяной банке с добавлением консерванта.
Также набирают популярность сырные снеки, не требующие хранения в холодных условиях. Их удобно брать с собой, поэтому в магазинах этот товар можно встретить в прикассовой зоне.
Молочные продукты, обогащенные витаминно-минеральными комплексами
В последние годы на рынке появились новые виды функциональных молочных продуктов, например, «ночное молоко», которое получают во время ночной дойки. По словам производителей, такой продукт способствует быстрому засыпанию.
Исследования показывают, что в молоке, собранном ночью, повышен уровень мелатонина и триптофана. Эти вещества обладают седативным свойством и улучшают качество сна. Однако эффективность продукта во многом зависит от индивидуальных особенностей человека.
Разные производители обогащают молочные продукты дополнительными витаминами и минералами. Витамины D, E, K, A, витамины группы В и минералы — кальций, магний, йод и цинк — самые популярные добавки. Например, все продукты Растишка содержат витамин D и кальций — первый помогает усваиваться второму.

Такие продукты помогают восполнить дефициты и поддерживают здоровье костей и обмен веществ. Чтобы избежать передозировки от употребления таких продуктов на постоянной основе, лучше проконсультироваться с доктором.
Молочные продукты без участия животных
Одно из перспективных направлений животноводства — производство молочных продуктов без участия животных с помощью прецизионной ферментации. Упрощенно процесс производства состоит из этапов:
- Выделяют ген, который отвечает за производство молочного белка и «подсаживают» его в микроорганизмы.
- «Кормят» модифицированные микроорганизмы простыми сахарами. По мере роста, они начинают производить молочные белки.
- Извлекают и очищают белок. Он становится идентичным натуральным белкам, которые содержатся в коровьем молоке.
- Насыщают молочные белки жирами, витаминами и минералами, чтобы создать привычный кисломолочный продукт.
Стартапы активно вкладываются в развитие и масштабирование этой дорогостоящей технологии, делая акцент на:
- экологичности — производство таких молочных продуктов требует меньше энергии и не нуждается в пастбищах;
- безопасности и минимизации рисков — процесс не зависит от погоды и здоровья животных;
- перспективах удешевления технологии — производители надеются, что в скором времени себестоимость молока будет такой же, как традиционного.
Но по прогнозам, новая технология не вытеснит традиционное животноводство. Более реалистичный сценарий — формирование комбинированного рынка молочной продукции.
Но это еще не все новинки, которые мы увидим на полках магазинов. Производители продолжают разрабатывать новые технологии, придумывать оригинальные вкусы и усовершенствовать привычные продукты и способы производства. А чем еще удивит молочная индустрия — читайте во второй части материала, которую мы скоро выпустим!



